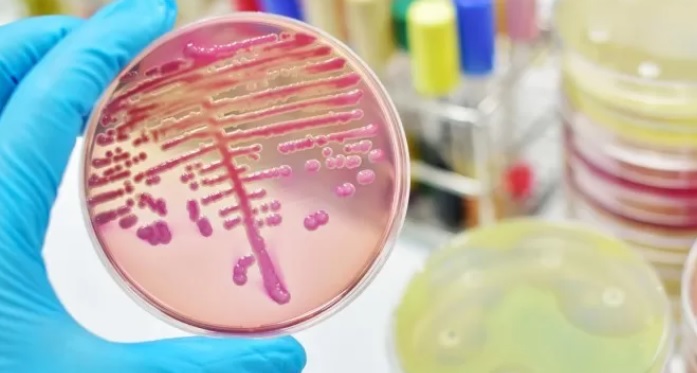

Detectan y contienen brote de una bacteria resistente a todas las drogas en Argentina
El Servicio Antimicrobianos del Instituto Nacional de Enfermedades Infecciosas (INEI)-Anlis Malbrán informó a la comunidad médica y científica que fue detectado y controlado un brote de una bacteria resistente a todas las drogas disponibles en Argentina, lo que para especialistas “es un llamado de atención acerca de que la resistencia antimicrobiana no es problema a futuro sino que está sucediendo aquí y ahora”.
En esta oportunidad se trató de la bacteria Klebsiella pneumoniae que fue detectada en muestras de orina tomadas entre el 28 de agosto y el 15 de septiembre de 2022 de tres pacientes con infección urinaria que habían tenido un trasplante renal en un centro de salud de la ciudad de Buenos Aires.
El informe, que se publicó en estos días, detalla que los pacientes fueron tratados “en forma compasional”, es decir para aliviar los síntomas, con tres antibióticos y que “sobrevivieron aunque perdieron sus injertos renales”.
“El brote pudo ser contenido, sin casos fatales y sin reportes de nuevas infecciones PDR (pan-drogo resistentes, es decir, resistentes a todas las drogas) hasta la fecha”, señala el documento.
La Klebsiella pneumoniae es una especie dentro del género bacteriano Klebsiella, compuesto por bacterias Gram negativas de la familia Enterobacterias, que desempeñan un importante papel como causa de las enfermedades infecciosas que aparecen ante la baja de defensas.
En este caso se trataba de una bacteria “pan-drogo resistente”, lo que significa que es resistente a todas las drogas disponibles.
“Esto es la evidencia de que ya dentro del territorio nacional hay situaciones de pan-drogo resistencia, es decir, de infecciones que no tienen alternativa terapéutica; esto demuestra que es un problema mundial que también es nuestro y que requiere llevar a cabo un conjunto de acciones en las que cada sector se comprometa con su parte”, sostuvo en diálogo con Télam la médica infectóloga Leda Guzzi.
Guzzi, integrante de la Sociedad Argentina de Infectología (SADI), señaló que “estos datos remarcan la importancia del concepto de Una Salud, como sostiene la OMS y que implica comprender que la salud humana está estrechamente relacionada con la salud animal y ambiental, y que la comunidad tiene un rol que va desde el descarte de antimicrobianos, hasta el cuidado de ambiente, incluyendo a los actores civiles que intervienen en la producción alimentaria, es decir, que excede al ámbito médico-científico estrictamente”.
En este sentido, recordó que en agosto pasado el Congreso sancionó la Ley 27.680 de Prevención y Control de la Resistencia Antimicrobiana que tiene como uno de sus objetivos fundamentales el uso responsable de los antibióticos, tanto en salud humana como animal y la regulación en su expendio.
Entre los principales puntos de la ley figuran optimizar el uso de medicamentos antimicrobianos; mejorar la sensibilización y los conocimientos en materia de resistencia a los antimicrobianos; reforzar la vigilancia y la investigación en esta temática, y prevenir y reducir la incidencia de las infecciones asociadas al cuidado de la salud.
Y destacó como otro tema importante “el control de las aguas, donde hay que evaluar la carga bacteriana, el fenotipo de esas bacterias, la resistencia que presenten o no, pero también hay que controlar lo que se descarta en las aguas que después se consumen, tanto en el mundo animal como en el humano”.
En este contexto, el comunicado del Servicio Antimicrobianos del INEI-Anlis Malbrán va en la línea con las acciones de vigilancia y en sus conclusiones finales advierte que “el hallazgo de cepas PDR (pan-drogo resistentes) debe ser considerado de alto riesgo epidemiológico”.
“Por ello, se requiere del máximo esfuerzo de todos los integrantes de los equipos de salud, en especial del Comité de Control de Infecciones, para la rápida detección y contención de la diseminación de cepas PDR”, indicó el texto.
En diciembre, la OMS alertó que un 8% de las infecciones en sangre intrahospitalarias por la bacteria Klebsiella pneumoniae se volvió resistente a los antibióticos de último recurso, lo que aumenta el riesgo de muerte debido a que se tornan inmanejables.
El trabajo -que fue el primer informe que el Sistema Mundial de Vigilancia de la Resistencia y el Uso de Antimicrobianos (GLASS, por sus siglas en inglés) realizó haciendo un análisis de las tasas de RAM en 87 países – mostró altos niveles (superiores al 50%) de resistencia en bacterias que con frecuencia causan infecciones del torrente sanguíneo en hospitales, como Klebsiella pneumoniae y Acinetobacter spp.
Guzzi advirtió que “una vez que emerge una bacteria de estas características puede haber una dispersión a través del contacto, a través de las manos del personal, por eso es tan importante el lavado de manos en toda la población y en las instituciones en particular”.
Como expresó la infectóloga, la resistencia antimicrobiana -es decir la capacidad de bacterias, hongos, virus, de volverse resistentes a la medicación- es una problemática global y se estima que para el año 2050 puede convertirse en la primera causa de muerte a nivel mundial, “si no se genera una respuesta mundial conjunta y sistematizada”.
En ese sentido, desde la OMS, en su sesión del Comité Regional para las Américas, se resolvió el año pasado aprobar el plan sobre RAM y su aplicación en el contexto de cada país a través del diseño y adopción de medidas para enfrentar este problema de origen multifactorial.